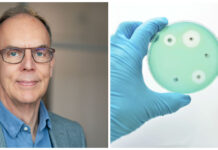
”Det kan inte bli mycket värre”

Utvecklingen av ett blodprov som hittar Alzheimers sjukdom lika träffsäkert som ryggmärgsvätskeprov har tagit ett nytt viktigt steg. Forskare på Skånes universitetssjukhus visar att provet fungerar lika bra i den vanliga sjukvården som i forskningsstudier.
Detta kan betyda stor skillnad inte minst för primärvårdens möjligheter att hitta Alzheimers sjukdom i tidiga stader.
– Det här kan få stor betydelse för alla de som söker till vården med minnespåverkan och misstänkt alzheimer, framhåller forskarna bakom studien i ett pressmeddelande.
Hittar Alzheimers sjukdom träffsäkert
Läkemedelsvärlden har även tidigare rapporterat om de pågående forskningsansträngningarna för att få fram ett lättanvänt, säkert diagnostiskt test för Alzheimers sjukdom. Flera svenska forskargrupper deltar i detta arbete där utvecklingen nu går snabbt.
Vid Skånes universitetssjukhus i Lund finns professor Oskar Hansson och docent Sebastian Palmqvist och deras medarbetare. Gruppen har sedan 2019 varit med och utvecklat ett blodtest för Alzheimers sjukdom. Testet mäter nivåerna av ämnet fosfo-tau217 i kombination med kvoten mellan två former av proteinet amyloid-beta.
Tidigare studier har visat att blodtestet är mycket bra på att påvisa alzheimerförändringar redan innan sjukdomen börjar visa sig. Metoden är lika säker eller bättre än de ryggmärgsvätskeprov som man i dag normalt använder och som är betydligt besvärligare att ta.
Studie vid vårdcentraler och minneskliniker
I den nu aktuella studien undersökte forskarna hur bra blodtestet, som heter APS2, är när det används i den vanliga sjukvården. Studien är publicerad av tidskriften Jama.
Totalt 1 213 personer med misstänkt Alzheimers sjukdom deltog i studien. Närmare 700 av dem var utreddes vid någon av minnesklinikerna i Lund och Ängelholm. Övriga hade sökt vård för minnesproblem vid någon av de 17 vårdcentraler som medverkade.
Läkarna undersökte patienterna som också fick ta både blodtestet APS2 och ryggmärgsvätskeprov.
Innan läkarna fick se provsvaren bad forskarna dem att bedöma om patienten hade tidig Alzheimers sjukdom eller ej.
Viktigt för läkemedelsutveckling
Blodtestet hittade 90 procent av dem som enligt ryggmärgsvätsketestet hade alzheimerförändringar. Primärvårdsläkarna hittade 61 procent och specialistläkarna vid minnesmottagningarna 73 procent.
– Detta belyser behovet av bra och kostnadseffektiva diagnostiska verktyg, framför allt i primärvården, och vilken förbättring som kan uppnås om man börjar använda ett sådant här blodprov i sjukvården, säger Sebastian Palmqvist, som ledde studien tillsammans med Oskar Hansson.
Båda framhåller att de nya bromsmediciner som är på gång, exempelvis omdiskuterade lekanemab, gör att tidig diagnos av Alzheimers sjukdom nu blir allt viktigare.
– Men det är också viktigt för att kunna forska fram nya behandlingar, säger Oskar Hansson.
I vården om ett par år
Att utesluta alzheimer genom ett enkelt, träffsäkert blodprov som kan göras inom primärvården blir också av vikt för patienten och den behandlande läkaren. Minnessvårigheter kan bero på andra behandlingsbara orsaker, till exempel depression eller utmattningssyndrom.
– Nästa steg blir nu att ta fram tydliga kliniska riktlinjer för hur blodprovet ska användas i sjukvården. Blodprovet beräknas bli tillgängligt för läkare i Sverige att beställa till hösten, och jag tror man då kommer börja använda det ganska snart på specialiserade minneskliniker. Det kommer nog ta cirka 1-2 år innan riktlinjer och utbildningsinsatser är på plats inom primärvården, säger Oskar Hansson.